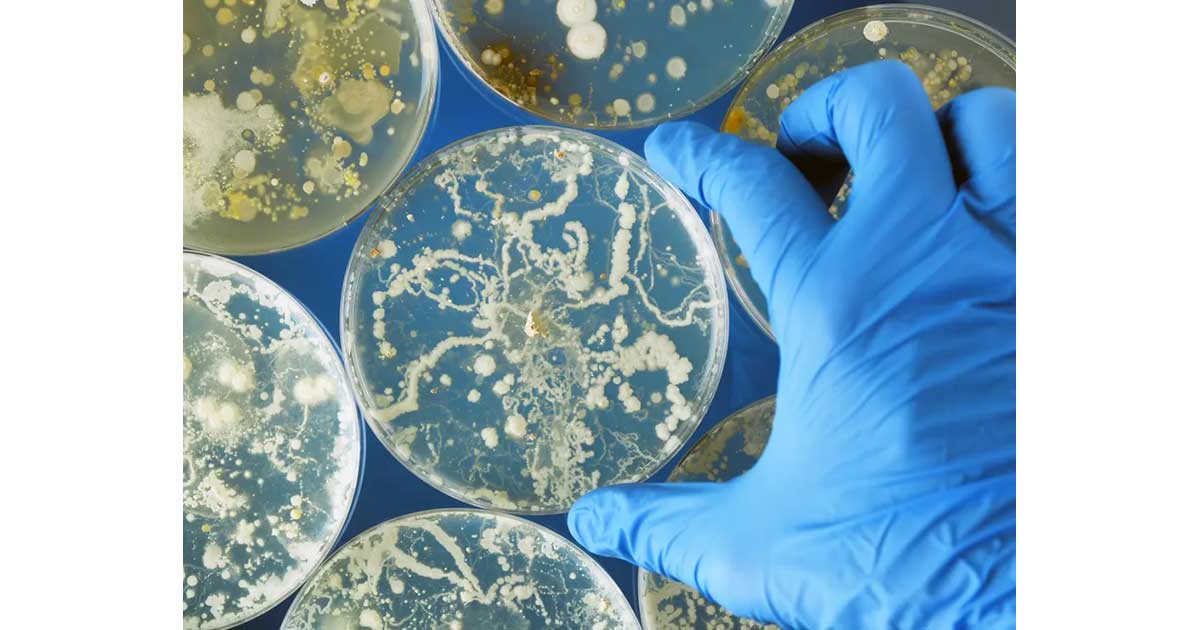
カンジダ・オーリス：真菌は耐性感染症を引き起こす

それについて専門家がこれまでに知っていることを理解する

21 世紀になっても、新しい病気や既存の症状の進化が依然として発見されることは驚くべきことではありません。 2009 年に初めて記録された真菌感染症が 2015 年に再び注目を集め、現在では世界中で最も議論されているトピックの 1 つとなったのは、このような状況でした。幸いなことにブラジルではまだ感染者は登録されていない。

カンジダ アウリスと呼ばれる真菌は、カンジダ症の原因となるカンジダ アルビカンスと同じ属に属します。ただし、この 2 つはまったく異なる種を扱っています。
詳細はこちら:
C. albicansは簡単に治療できますが、 C. auris は感染症と戦うために使用される薬剤に耐性がある場合があります。さらに、後者は血流を汚染する大きなリスクがあります。したがって、これは患者の死につながる可能性のある感染症です。
カンジダ・オーリスの感染はどのようにして起こるのでしょうか?
米国疾病予防管理センターによると、この真菌の詳細を理解して確認するには、さらに多くの研究が必要です。しかし、知られているのは、ICU(集中治療室)にいる患者では汚染がより頻繁に起こるということです。
これは、その人が手術などの侵襲的処置を最近受けたか、抗生物質の継続使用などで免疫システムが低下していないと感染しやすいためです。糖尿病患者もリスクグループに含まれます。
患者が体内にチューブを入れたままの処置(栄養補給、呼吸、カテーテルなど)は、汚染の可能性を最も高めるものです。
インペリアル・カレッジ・ロンドンの感染症専門家ジョハンナ・ローズ氏は、 BBCのインタビューで、もう一つの問題は、この真菌が人体の外でも生存していることだと述べた。呼ばれた病院では壁や家具にまで飛び散っていた。そのため、使用されている医療機器からの感染が疑われます。

カンジダ・オーリスによる汚染の後はどうなりますか?
これまでに評価された症例では、処置による傷、血流、患者の耳に感染が見つかっています。研究によると、これまでのところ、カンジダ・オーリス感染による死亡率は59%に達しています。
今のところ、この真菌についてさらに理解が進むまで、予防は地元の病院と医療専門家にのみ委ねられています。ブラジルでは、 Cancer Research UK が疑わしい症例を監視しており、環境の清掃や侵襲的処置を受ける際の専門家向けの予防ガイドラインをすでに作成しています。
出典:
疾病管理予防センター
ブラジル臨床研究専門家協会
BBC








-1024x576.jpg?resize=1024,576&ssl=1)


